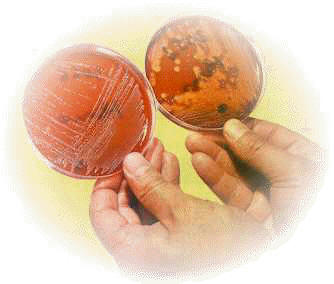
Cultivos bacterianos en placas de Petri
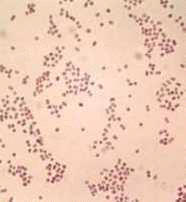

Microbiología y enfermedad
Proyecto Salón Hogar
 Como
ya vimos en la segunda unidad, fue Louis Pasteur quien demostró que algunas
bacterias son la causa de ciertas enfermedades infecciosas o contagiosas. Antes
de él, muchos científicos y médicos ya tenían argumentos en favor de la
teoría de los gérmenes como causa
de enfermedad.
Como
ya vimos en la segunda unidad, fue Louis Pasteur quien demostró que algunas
bacterias son la causa de ciertas enfermedades infecciosas o contagiosas. Antes
de él, muchos científicos y médicos ya tenían argumentos en favor de la
teoría de los gérmenes como causa
de enfermedad.
 Rober
Koch, médico microbiólogo alemán descubridor del agente causante de la
tuberculosis y del cólera, estableció los llamados
postulados de Koch para las enfermedades infecciosas,
que señalan:
Rober
Koch, médico microbiólogo alemán descubridor del agente causante de la
tuberculosis y del cólera, estableció los llamados
postulados de Koch para las enfermedades infecciosas,
que señalan:
- El agente
causante (el microorganismo) ha de encontrarse siempre asociado a la
enfermedad.
- El
microorganismo ha de ser aislado a partir de lesiones y obtenido en
cultivo puro en el laboratorio.
- Este cultivo
puro inoculado a un animal susceptible debe producir enfermedad.
- Se debe
aislar el mismo microorganismo en cultivo puro realizado a partir de
lesiones del animal infectado experimentalmente.
- Se debe
demostrar la aparición de defensas específicas contra el agente causante
tanto en el enfermo como en el animal infectado experimentalmente.
El término
infección implica acción competitiva y antagonista entre
dos seres vivos, el huésped y el parásito. Si
el parásito tiene éxito, aparece la enfermedad; cuando esto ocurre recibe el
nombre de agente patógeno.
No deben confundirse los términos
infección e infestación. Esta
última palabra sólo indica presencia de
parásitos animales sobre o dentro del cuerpo (ectoparásitos o endoparásitos).
Por ejemplo: un perro puede ester infestado de garrapatas y, sin embargo, no
haber contraído ninguna enfermedad infecciosa. Por otro lado, un parásito
infestante como la pulga (foto de la izquierda), el mosquito Anopheles
o la garrapata (foto de
de
parásitos animales sobre o dentro del cuerpo (ectoparásitos o endoparásitos).
Por ejemplo: un perro puede ester infestado de garrapatas y, sin embargo, no
haber contraído ninguna enfermedad infecciosa. Por otro lado, un parásito
infestante como la pulga (foto de la izquierda), el mosquito Anopheles
o la garrapata (foto de
 la
derecha), puede transmitir enfermedades microbianas como la peste. En este caso
se habla de insecto (o cualquier otro animal)
vector.
la
derecha), puede transmitir enfermedades microbianas como la peste. En este caso
se habla de insecto (o cualquier otro animal)
vector.
La
patogenicidad se puede definir como la capacidad que tienen los
microorganismos para penetrar en el huésped y producirle enfermedad. Un
microorganismo patógeno puede serlo en mayor o menor grado, hablándose entonces
de virulencia. Así pues, un
microbio será muy virulento si su capacidad para producir enfermedad es muy alta.
La virulencia de un agente patógeno depende de:
- Las propiedades inherentes al propio
microorganismo.
- En algunos casos el microbio produce en el
enfermo toxinas o sustancias venenosas para determinadas
células del hésped. Esta toxina puede detectarse en la sangre del enfermo,
hablándose entonces de toxemia.
- En otros casos, la enfermedad no se adquiere
por toxinas sintetizadas por microbios en el organismo humano, sino por la
ingestión de alimentos contaminados con toxinas.
- Otras veces no se producen toxinas, pero sí
alteraciones fisiológicas y metabólicas variables según la enfermedad
infecciosa, y que se manifiestan con unos síntomas determinados.
- La virulencia de algunos microorganismos se
debe a determinadas enzimas que favorecen la capacidad de
penetración. Así por ejemplo, la colagenasa destruye el colágeno de
la piel, huesos, cartílagos o músculos. La lecitinasa provoca la lisis de
los eritrocitos, y la coagulasa activa el proceso de coagulación de la
sangre; todas estas acciones favorecen directa o indirectamente la expansión
del agente patógeno en el huésped.
www.proyectosalonhogar.com
Como
ya vimos en la segunda unidad, fue Louis Pasteur quien demostró que algunas
bacterias son la causa de ciertas enfermedades infecciosas o contagiosas. Antes
de él, muchos científicos y médicos ya tenían argumentos en favor de la
teoría de los gérmenes como causa
de enfermedad.
Como
ya vimos en la segunda unidad, fue Louis Pasteur quien demostró que algunas
bacterias son la causa de ciertas enfermedades infecciosas o contagiosas. Antes
de él, muchos científicos y médicos ya tenían argumentos en favor de la
teoría de los gérmenes como causa
de enfermedad.  Rober
Koch, médico microbiólogo alemán descubridor del agente causante de la
tuberculosis y del cólera, estableció los llamados
postulados de Koch para las enfermedades infecciosas,
que señalan:
Rober
Koch, médico microbiólogo alemán descubridor del agente causante de la
tuberculosis y del cólera, estableció los llamados
postulados de Koch para las enfermedades infecciosas,
que señalan:  de
parásitos animales sobre o dentro del cuerpo (ectoparásitos o endoparásitos).
Por ejemplo: un perro puede ester infestado de garrapatas y, sin embargo, no
haber contraído ninguna enfermedad infecciosa. Por otro lado, un parásito
infestante como la pulga (foto de la izquierda), el mosquito Anopheles
o la garrapata (foto de
de
parásitos animales sobre o dentro del cuerpo (ectoparásitos o endoparásitos).
Por ejemplo: un perro puede ester infestado de garrapatas y, sin embargo, no
haber contraído ninguna enfermedad infecciosa. Por otro lado, un parásito
infestante como la pulga (foto de la izquierda), el mosquito Anopheles
o la garrapata (foto de
la
derecha), puede transmitir enfermedades microbianas como la peste. En este caso
se habla de insecto (o cualquier otro animal)
vector.
la
derecha), puede transmitir enfermedades microbianas como la peste. En este caso
se habla de insecto (o cualquier otro animal)
vector.